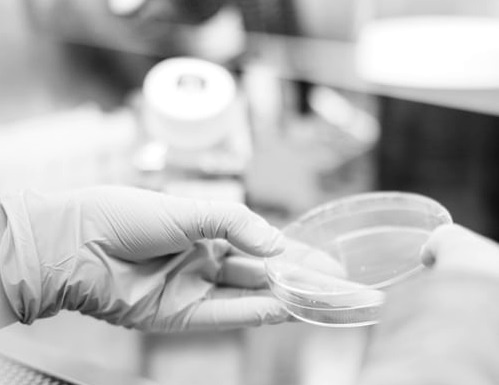

Charla: Reprodución humana
Actividade enmarcada dentro do ciclo temático "Realidades invisibles" co que queremos concienciar, visibilizar e contribuír a paliar os retos que ten a nosa sociedade, todos eles recollidos nos Obxectivos de Desenvolvemento Sostible.
A quen vai dirixido?:
Todos os públicos
A quen vai dirixido:
Para público en xeral
Cando:
04/03/2020
Entrada libre ata completar a capacidadeXa rematou
Horario:
de 19.00 a 20.00 horas
Enderezo:
Biblioteca Municipal Fórum Metropolitano. Rúa Río Monelos 1. 15006 A Coruña
Contacto:
Tel.: 981 184 298
ODS núm. 3: Garantir unha vida sa e promover o benestar para todas/os e todas as idades
Desexar ter un fillo e non poder alcanzar ese desexo de modo espontáneo é unha fonte de tensión e angustia, o obxectivo desta charla é axudar a resolver as dúbidas que poidan xurdir arredor destes procesos e dese modo intentar que este camiño, que con frecuencia é longo, sexa o menos dificultoso posible.
Segundo os estudos epidemiolóxicos a esterilidade afecta a unha de cada seis parellas en idade reprodutiva e esta cifra está a experimentar unha evolución crecente.
Que é a esterilidade? É o mesmo a esterilidade que a infertilidade? Cales son os principais factores que afectan a esta evolución crecente? Cando debo consultar a un especialista? En que consiste un estudo básico de esterilidade?
Estes son algúns dos puntos básicos que trataremos. Falaremos da idade como unha das principais causas de esterilidade: idade reprodutiva social fronte a idade reprodutiva biolóxica.
Trataremos temas tan en auxe como a preservación de fertilidade ou a doazón de ovocitos, expoñeremos os seus puntos a favor e en contra.
Patricia Buyo, a encargada desta charla, é médica especialista en xinecoloxía e obstetricia, na actualidade traballa no CHUAC e desde hai ano e medio con dedicación preferente na Unidade de Reprodución Humana.
Actividades relacionadas
- Charla: Camiñantes do medo. Pasos, persoas e dereitos (05/02/2020 en Biblioteca Municipal Fórum Metropolitano)
- Charla: Non teño tempo para min. Como organizarme mellor? (09/03/2020 en Biblioteca Municipal Fórum Metropolitano)
- Charla: Voluntariado en África. Un voluntariado diferente (19/02/2020 en Biblioteca Municipal Fórum Metropolitano)
- Obradoiro: Acoso escolar. Non sexas cómplice (18/03/2020 en Biblioteca Municipal Fórum Metropolitano. Inscricións dende o 11/03/2020 ata o 18/03/2020)
Tamén che pode interesar
Tamén che pode interesar...

Homenaxe coral a Marcial del Adalid no bicentenario do seu nacemento
Cando:
11/04/2026
Inscricións:
Ata o 11/04/2026
Entrada libre ata completar a capacidade

#LunsDeEncontros: Presentación do libro “Madriña” de Antonio Tizón
Cando:
20/04/2026
Inscricións:
Acceso libre até completar capacidade

#LunsDeEncontros: Presentación do libro “El hijo de la roca y el fuego” de Jacinto Ruíz
Cando:
27/04/2026
Inscricións:
Acceso libre ata completar capacidade

Presentación do libro “Ata que os mares sequen. Unha Escocia en clave galega” de Manuel Gago
Cando:
29/04/2026
Inscricións:
Acceso libre até completar capacidade

#LunsDeEncontros: Presentación do libro “Caer para Ser” de Lydia Parga
Cando:
18/05/2026
Inscricións:
Acceso libre ata completar capacidade
Tes un navegador demasiado antigo!
Sentímolo pero o teu navegador é moi antigo para poder mostrar esta páxina. Debes de actualizalo ou usar un navegador compatible. Optimizamos esta web para Google Chrome, Mozilla Firefox, Opera, Safari e Microsoft Edge. Instalar agora un navegador compatible